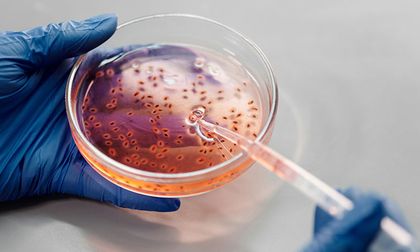
Puntos débiles en enterovirus abren la puerta a antivirales de amplio espectro

Cali, febrero 24 de 2026. Actualizado: martes, febrero 24, 2026 21:33
Nuevas investigaciones abren oportunidades
Puntos débiles en enterovirus abren la puerta a antivirales de amplio espectro
Enterovirus representan una familia de virus comunes que van de cuadros leves de resfriado a meningitis o miocarditis. Su extraordinaria capacidad de mutación y sus múltiples estrategias de infección obstaculizan el desarrollo de vacunas y tratamientos efectivos.
Un equipo internacional liderado por el CSIC y el NIAID aplicó un método de cribado genético ultrarrápido, deep mutational scanning, para evaluar más de 80 mil mutaciones en dos enterovirus humanos de gran relevancia sanitaria: el Enterovirus A71 y el Coxsackievirus B3.
El estudio mapeó cómo cada cambio afecta la replicación y el ensamblaje viral. Los científicos descubrieron un núcleo proteico altamente conservado y un nuevo bolsillo en la proteína 2C, regiones con escasa tolerancia a variaciones.
Al ser partes esenciales para el ciclo de vida del virus, se posicionan como dianas terapéuticas de amplio espectro.
Regiones vulnerables y nuevas dianas terapéuticas
El núcleo estable y la cavidad de la 2C ofrecen áreas donde un antiviral puede anclarse sin que el virus escape fácilmente mediante mutaciones.
Atacar estas zonas clave podría bloquear la multiplicación viral y reducir el riesgo de resistencias a los fármacos.
Estos hallazgos permiten ahora diseñar cribados virtuales in silico para identificar compuestos capaces de encajar en el bolsillo de la proteína 2C y neutralizar múltiples enterovirus.
En el futuro, estos avances contribuirán a reforzar la prevención y el control de enfermedades asociadas a estos patógenos.













